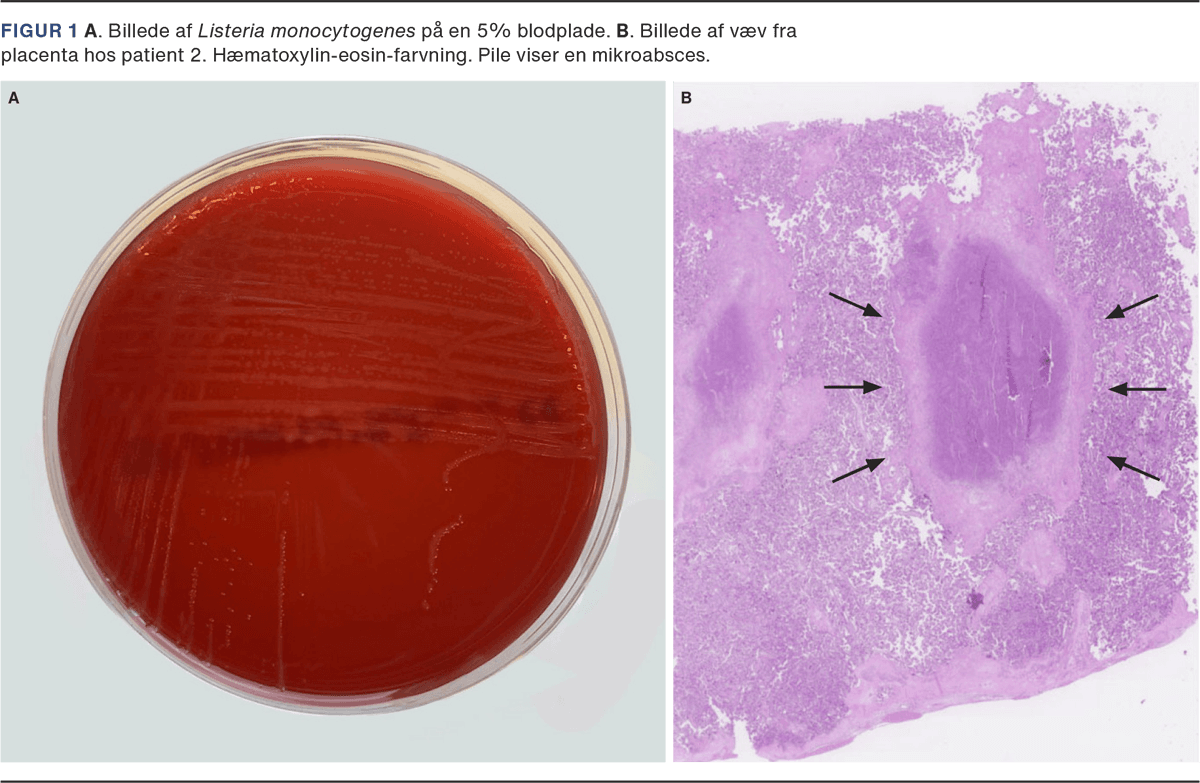

Immunsuppression, graviditet og listerainfektion
Lilian Bostlund Olsen1, Pernille Langkjær Gormsen2, Britta Blume Dolleris3, Anne-Louise Lykke Nielsen3, Hanne Katrine Rosbach3, Kurt Fuursted4 & Lise Lotte Torvin Andersen3
Listeria-infektion er en fødevarebåren infektion, som skyldes den intracellulære grampositive stav Listeria monocytogenes. Smitte sker oftest via fødevarer, men kan overføres fra mor til foster. Hos immunsvækkede, gravide, fostre og nyfødte kan infektionen blive alvorlig og bl.a. være årsag til sepsis, abort eller dødfødsel. De fleste tilfælde registreres ikke, da patienter typisk har lette symptomer som feber, influenzasymptomer og/eller diarré. Der registreres ca. 50 tilfælde årligt i Danmark, hovedsageligt i spinalvæske og bloddyrkninger, heraf 1-3 tilfælde hos gravide [1, 2].
Begge patienter var kendt med inflammatorisk tarmsygdom og i immundæmpende behandling med hhv. adalimumab og azathioprin.
Patient 1 henvendte sig i gestationsuge (GA) 35+0 og patient 2 i GA 29+6. Begge efter en uges symptomer med hhv. let og høj feber og utilpashed. Patient 1 var sparsomt klinisk påvirket og blev sendt hjem efter blodprøver og bloddyrkninger (BD). Patient 2 blev indlagt akut og overflyttet til intensiv afdeling grundet septisk shock. Begge havde positive BD med L. monocytogenes (Figur 1 A).
Efter fund af positive BD blev patient 1 indlagt og fik i.v.-behandling med ampicillin i tre uger samt gentamicin de første tre døgn. Fraset fund af ekkogene tarme ved UL-skanning var undersøgelser og kardiotokografi (CTG) normale. Man foretog UL hver 3.-4. dag og CTG hver 12. time. Grundet fuldbåren graviditet og klinikeres kendskab til risiko for mikroabscesser i placenta blev patienten igangsat efter ti dage. Hun fødte vaginalt i GA 37+2 en dreng på 3.375 g.
Patient 2 fik initialt meropenem grundet septisk shock og dissemineret intravaskulær koagulation. Blev skiftet på dag to til i.v. ampicillin og gentamicin (de første tre døgn), hvorpå den kliniske tilstand vendte. Efter to døgn kom patienten på stamafsnit, hvor hun fik kontinuerlig CTG-måling i syv dage og herefter UL og CTG, som ved patient 1. Efter tre ugers i.v. ampicillin blev der skiftet til tablet amoxicillin i stedet for ophør af behandling, grundet bekymring hos patienten. Hun fødte en pige på 2.225 gram ved kejsersnit i uge 33+5 efter en type IV-allergisk reaktion, opstået kort efter påbegyndt amoxicillin. Barnet blev forløst grundet patologisk CTG.
Hos begge patienter var placenta uden synlige forandringer og blev sendt til patologisk undersøgelse med fund af mikroabscesser forenelige med listeriainfektion (Figur 1 B). Ved PCR fra væv omkring abscesserne fandt man DNA fra L. monocytogenes hos begge.
Barn 1 havde kortvarigt continuous positive airway pressure (CPAP)-behov efter fødslen. Havde normal Apgarscore og var klinisk upåvirket gennem hele indlæggelsen. Lumbalpunktur (LP) blev taget i første levedøgn og infektionstal og BD umiddelbart efter fødslen. Efter prøvetagning fik barnet ampicillin i syv døgn og gentamicin i tre døgn i neonatal meningitisdosering. Spinalvæske og BD var uden vækst, og de daglige blodprøver vedvarende normale.
Barn 2 havde kortvarigt CPAP-behov og et lille iltkrav, normal Apgarscore og klinisk tilstand svarende til præmaturt barn. Der blev udført LP, blodprøver, samt BD, og man afventede opstart af antibiotika. Infektionstal blev taget dagligt i en uge, og de forblev normale. Spinalvæske og BD var dyrkningsnegative. Patienten havde et forventeligt indlæggelsesforløb efter præmaturitet og blev udskrevet tre uger senere i god trivsel.
Ingen af børnene fik yderligere opfølgning.
Fælles for ovenstående cases ud over graviditet er, at begge patienter fik immundæmpende medicin: en kendt risikofaktor for listeriainfektion. Sygdommen optræder sporadisk med 1-3 årlige cases hos gravide i Danmark. Erfaring er derfor svær at opbygge og en sikker, standardiseret tilgang hos gravide med feber er derfor væsentlig. I begge cases var bloddyrkning essentiel for diagnostikken.
Den antibiotiske behandling er veletableret og belyst i flere studier. De fleste gravide har et benignt forløb, men fosterets prognose afhænger af, hvornår i graviditeten smitte forekommer, og om relevant antibiotisk behandling administreres [3, 4]. Monitorering og opfølgning af den gravide og fosteret er ikke velbeskrevet, og på baggrund af indeværende cases er der lavet grundig litteraturgennemgang, udgivet som en statusartikel i aktuelle nummer. Begge patienter blev fulgt med CTG hver 12. time og UL-skanninger hver 3.-4. dag med henblik på tidlig opsporing af infektionstegn. Begge børn overlevede uden mén. Da patient 1 blev forløst før færdigbehandlet infektion, valgte man antibiotisk behandling af barnet i en uge efter fødslen. Hos patient 2 så man an uden behandling af barnet, da mater var færdigbehandlet ved fødsel.
Korrespondance Lise Lotte Torvin Andersen. E-mail: lise.lotte.andersen@rsyd.dk
Antaget 16. juni 2025
Publiceret på ugeskriftet.dk 6. oktober 2025
Interessekonflikter LTA oplyser økonomisk støtte fra eller interesse i STPS og DSOG. BBD oplyser økonomisk støtte fra eller interesse i Campus Pharma. Alle forfattere har indsendt ICMJE Form for Disclosure of Potential Conflicts of Interest. Disse er tilgængelige sammen med artiklen på ugeskriftet.dk
Taksigelser Iben Johnsen, Afdeling for Klinisk Patologi, Odense Universitetshospital takkes for god sparring og billeder af mikroabsces i placenta. Rune Micha Pedersen, Kasper Klein, Gitte Nyvang Hartmeyer og Flemming Rosenvinge, Klinisk Mikrobiologisk Afdeling, Odense Universitetshospital takkes for god faglig sparring til kasuistikken.
Referencer findes i artiklen publiceret på ugeskriftet.dk
Artikelreference Ugeskr Læger 2025;187:V05250386
doi 10.61409/V05250386
Open Access under Creative Commons License CC BY-NC-ND 4.0
In this case report on pregnancy-related listeriosis, two women with inflammatory bowel disease and immunosuppression are presented. Both were treated with intravenous ampicillin for three weeks and gentamicin for three days. Continuous fetal monitoring was performed every 12 hours and ultrasound every 3-4 days. Both infants, born at 37 and 33 weeks, required brief CPAP but were clinically unaffected and survived without sequelae. Infant 1 received antibiotics for one week as the mother was two weeks into her treatment regimen, while infant 2 was not treated as the mother had completed her regimen.